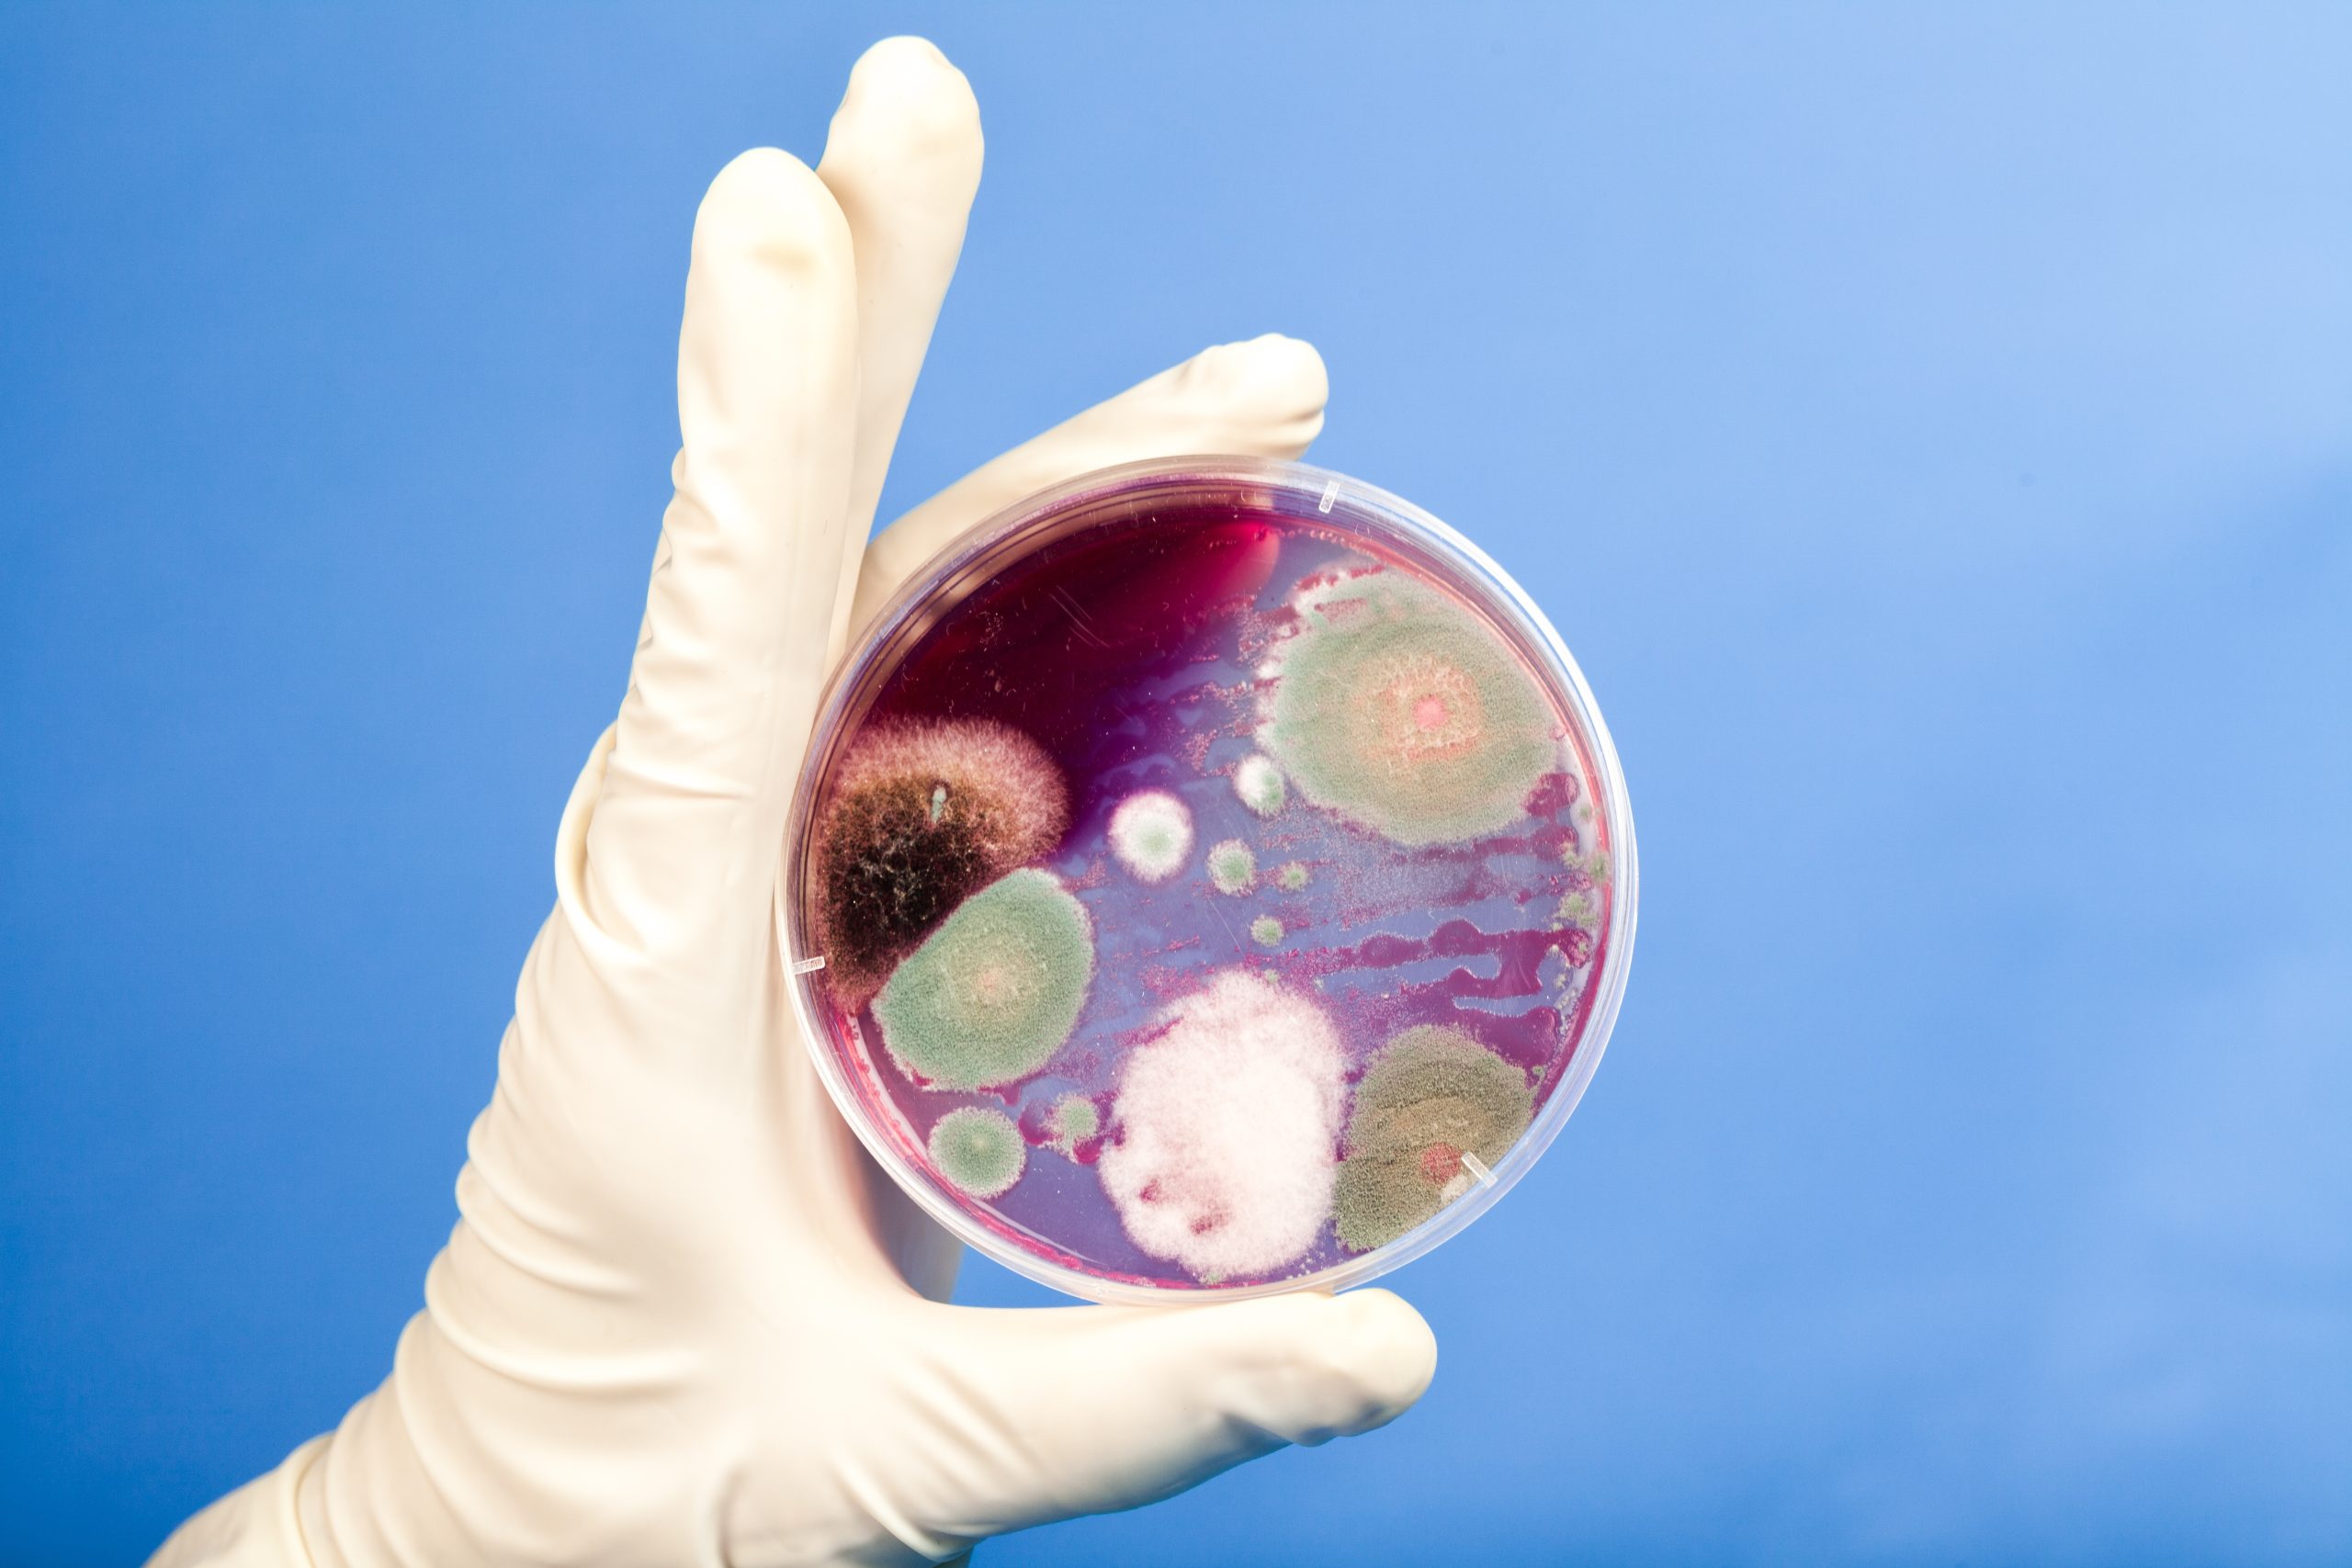

We think of our kitchen pantry as a safe, stable place to store our food. However, this dark and quiet space can be home to several hidden dangers that go beyond a simple expired can of soup. From invisible chemical contaminants to tiny insect pests, your pantry can harbor a variety of surprising health risks. By being aware of these five little-known dangers, you can ensure that your long-term food supply is not just well-stocked, but also safe.

1. Pantry Pests in Sealed Foods
You may think that an unopened bag of flour or a sealed box of cereal is safe from pests. However, many pantry pests, like flour weevils and Indian meal moths, can lay their eggs in the food at the processing plant. The eggs can then hatch inside the sealed package weeks or even months later. This is why you should always store your grains and flours in airtight, hard-sided containers to prevent an infestation from spreading.
2. Chemical Leaching from Old Plastic Containers
Many of us store our dry goods in old, reusable plastic containers. While this seems like a smart and sustainable choice, these older plastics can pose a hidden risk. Many old, hard plastic containers contain bisphenol A (BPA), a chemical that can disrupt the body’s hormones. The FDA has restricted its use, but it can still be found in older containers. It is safer to use glass or new, BPA-free plastic containers for your food storage.
3. Histamine in Canned Fish
Canned fish, like tuna and sardines, is a healthy and convenient pantry staple. However, if the fish is not kept at a proper, consistent temperature before it is canned, it can develop a high level of histamine. This can lead to a type of food poisoning known as scombroid poisoning. To reduce your risk, you should always discard any can of fish that seems “off” in any way.
4. Botulism from Improperly Canned Goods
The risk of botulism from commercially canned goods is very low, but it is not zero. This deadly toxin can grow in low-acid canned foods, like green beans or corn, that have been improperly processed. You should never eat from a can that is bulging, leaking, or deeply dented, especially near the seam. These are all signs that the can’s seal has been compromised and that the food inside could be deadly.
5. Cross-Contamination from Shelving
A subtle but important risk in a pantry is cross-contamination. Many people will store bags of raw produce, like potatoes and onions, on the upper shelves. These items can shed dirt and potentially bacteria onto the items below them. You should always store your raw, unwashed produce on the bottom shelf. You need to keep your ready-to-eat items, like boxes of crackers, on the shelves above them.
The pantry is the foundation of a well-run kitchen. It is a place that we trust to keep our food safe for the long term. By being mindful of these hidden dangers, we can ensure that this trust is well-placed. A little bit of vigilance and a few smart storage habits can go a long way in protecting the health and safety of your family.
Have you ever discovered a pest or another hidden danger in your pantry? What are your best tips for keeping your pantry safe and organized? Let us know!
What to Read Next
10 Lesser-Known Uses for Common Pantry Staples
7 Foods That Shoppers Grab First During Every Panic Rush
Here’s What Your Cart Full of Pantry Staples Says About Your Retirement Plan
7 Pantry Staples You Should Always Stock Two Weeks Before a Storm
5 Things You’re Refrigerating That Should Stay in the Pantry
The post 5 Little-Known Dangers Lurking in Your Pantry appeared first on Grocery Coupon Guide.